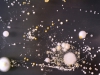
Скриншот/The Creators Project
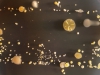
Скриншот/The Creators Project
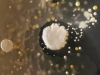
Скриншот/The Creators Project
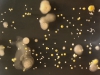
Скриншот/The Creators Project
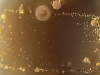
Скриншот/The Creators Project

Пусть они и незаметны, но мы знаем, что наши столы, телефоны, клавиатуры и другие предметы, использующиеся в повседневной жизни, покрыты бактериями.
Группа британских студентов из университета Суррея решили познакомиться с ними поближе и создали своеобразные произведения искусства, на которых на самом деле изображены бактерии, «живущие» на самом обычном смартфоне.
Ref.110.108.108.3485